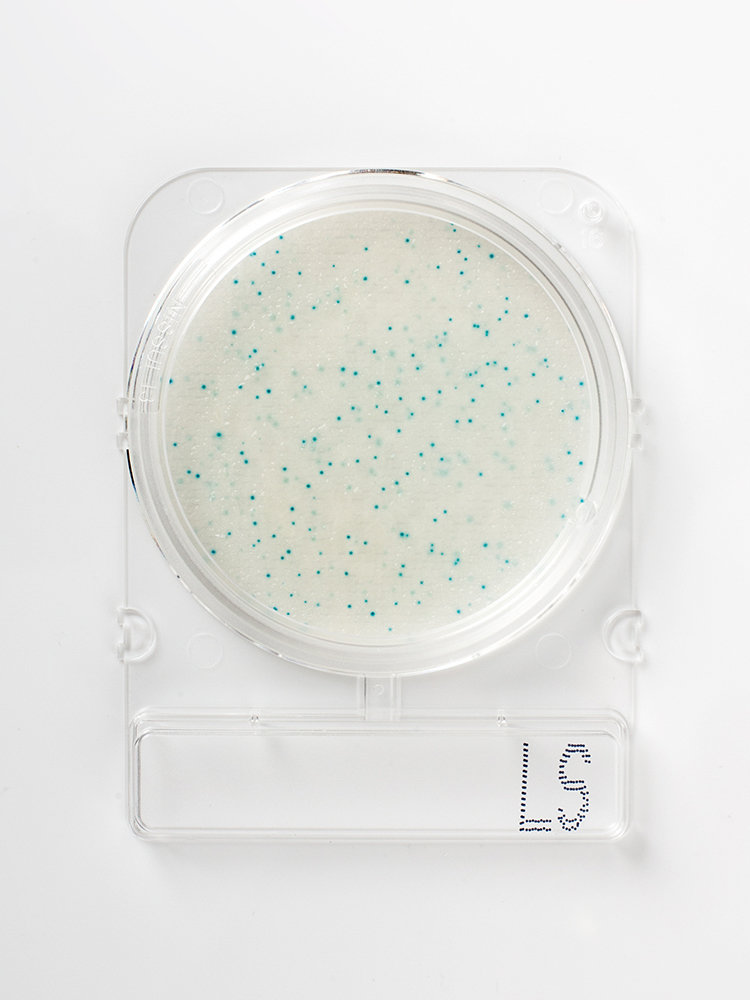

Compact Dry™ Prepared Media Plates - 54060
Compact Dry™ is a simple and safe procedure to determine and quantify microorganisms in food and beverage, raw materials, cosmetics and pharmaceutical industries and internal environmental monitoring. The ready-to-use Compact Dry™ chromogenic plates are suitable for both in-process and final product controls.
- Ready-to-use
- Self-diffusing media - no need for a spreader
- Room temperature storage vs competitive products with storage at temperatures less than or equal to 8ºC
- Rigid transparent plates with removable lid - no leakage
- Innovative stacking design
- Easy to label
- Ability to subculture without damage to colonies
- Widest available parameters and broadest application
- Convenient, fast and accurate results
Listeria spp. are Gram-positive, motile (under mesophilic conditions) bacteria of clinical importance due to their virulence activity. Listeria spp. are found in many environments, such as soil, water, decaying vegetation, and animals. Certain species, such as Listeria monocytogenes, can survive refrigeration and other food preservation methods. Listeria spp. can be transferred into the food chain when food is harvested or stored, and can remain as a contaminant throughout the food production process. This requires continuous monitoring of raw materials, processed product, and the food production environment.
You've got questions, we've got answers.
Reach out and let's see what we can do together.